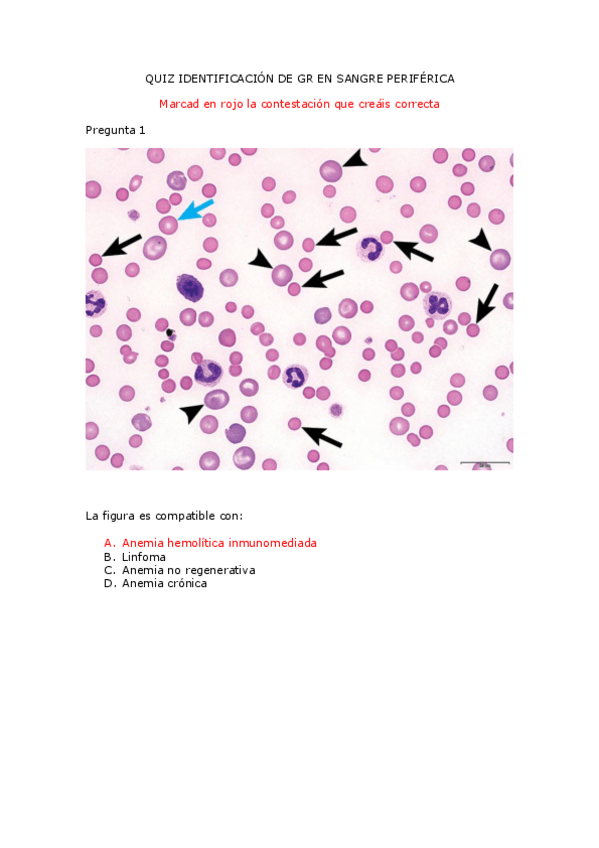

Patología General
He publicado nuevos apuntes de 2º Patología General: Dolor-rejas-resumen.pdf
apuntes
-
Trastornos respiratorios resumen
He publicado nuevos apuntes de 2º Patología General: Trastornos respiratorios resumen
He publicado nuevos examenes de 2º Patología General: examen-test-pg.docx.pdf
He publicado nuevos test de 2º Patología General: Cuestionario-hematologia.pdf
He publicado nuevos test de 2º Patología General: Test-PG-TEMAS-1-Y-2.pdf
He publicado nuevos apuntes de 2º Patología General: apuntes-PG-20232024.pdf
apuntes
-
Resúmenes patología general
He publicado nuevos apuntes de 2º Patología General: Resúmenes patología general
apuntes
-
Resúmenes PG
He publicado nuevos apuntes de 2º Patología General: Resúmenes PG
He publicado nuevos apuntes de 2º Patología General: tabla-respiratorio.pdf
examenes
-
EXÁMENES
He publicado nuevos examenes de 2º Patología General: EXÁMENES
He publicado nuevos practicas de 2º Patología General: cuestionario-practica-Hb.pdf
He publicado nuevos test de 2º Patología General: test-agrandamiento-abdominal.pdf
He publicado nuevos test de 2º Patología General: Cuestionario-fisiologia-del-aparato-circulatorio.pdf
He publicado nuevos apuntes de 2º Patología General: tabla-insuficiencias-y-estenosis-pg.pdf
examenes
-
Test rEPETIDORES-mantener continua
He publicado nuevos examenes de 2º Patología General: Test rEPETIDORES-mantener continua
He publicado nuevos apuntes de 2º Patología General: test-inmune-Temas-12-y-13.pdf
He publicado nuevos apuntes de 2º Patología General: Test-respiratorio-PG.pdf
He publicado nuevos examenes de 2º Patología General: cuestionario-repetidores-2-intentos.pdf
apuntes
-
Patología General
He publicado nuevos apuntes de 2º Patología General: Patología General
He publicado nuevos apuntes de 2º Patología General: PATOLOGIA-GENERAL.pdf
examenes
-
Recopilación Exámenes
He publicado nuevos examenes de 2º Patología General: Recopilación Exámenes
He publicado nuevos apuntes de 2º Patología General: Tabla-termorregulacion.pdf
He publicado nuevos apuntes de 2º Patología General: Resumen-Cardiaco-T21.pdf
examenes
-
Cuestionario Icteria y Agrandamiento
He publicado nuevos examenes de 2º Patología General: Cuestionario Icteria y Agrandamiento
He publicado nuevos examenes de 2º Patología General: Practica-C-Hematología.pdf
He publicado nuevos test de 2º Patología General: ECC01 Cuestionario cardiocirculatorio.pdf
He publicado nuevos practicas de 2º Patología General: Practica-F-Electrocardiograma.pdf
He publicado nuevos examenes de 2º Patología General: Cuestionario-EC_C01-Cardiocirculatorio.pdf
He publicado nuevos practicas de 2º Patología General: Práctica E(resuelta). Glóbulos blancos y plaquetas.pdf
He publicado nuevos practicas de 2º Patología General: Practica-D-Globulos-Resuelta.pdf
He publicado nuevos trabajos de 2º Patología General: Trabajo-de-la-clase-del-17/03.pdf
He publicado nuevos apuntes de 2º Patología General: PG3-REJAS-2023 Temas 12-16.pdf
He publicado nuevos examenes de 2º Patología General: Cuestionarios-EC_N04-y-EC_N05-PG.pdf
He publicado nuevos test de 2º Patología General: PEGOTODAS-PREGUNTAS.pdf
He publicado nuevos apuntes de 2º Patología General: CUESTIONARIO-ECN05.pdf
He publicado nuevos ejercicios de 2º Patología General: Trabajo-en-clase-2-PG-Reja.pdf
He publicado nuevos apuntes de 2º Patología General: Tema-1-5.-Apuntes.pdf
He publicado nuevos ejercicios de 2º Patología General: Trabajo-en-clase-PG-Reja.pdf
He publicado nuevos test de 2º Patología General: TODAS-PREGUNTAS3er-custionario-pego.pdf
He publicado nuevos examenes de 2º Patología General: Tercer-cuestionario-PG-EC_N03.pdf
He publicado nuevos apuntes de 2º Patología General: CUESTIONARIO-3-algunas.pdf
He publicado nuevos examenes de 2º Patología General: Segundo-cuestionario-PG-ECN02.pdf
He publicado nuevos examenes de 2º Patología General: Primer-cuestionario-PG-ECN01.pdf
He publicado nuevos examenes de 2º Patología General: Primer cuestionario-3-PG.pdf
He publicado nuevos examenes de 2º Patología General: Primer-cuestionario-2-PG.pdf
He publicado nuevos examenes de 2º Patología General: Primer-cuestionario-1-PG.pdf
apuntes
-
Teoría completa PG
He publicado nuevos apuntes de 2º Patología General: Teoría completa PG
He publicado nuevos apuntes de 2º Patología General: ESQUEMA-DEGRADACION-HEMOGLOBINA.pptx
He publicado nuevos apuntes de 2º Patología General: preguntas-examenes-con-respuesta.pdf
He publicado nuevos apuntes de 2º Patología General: patologia-desarrollo.pdf